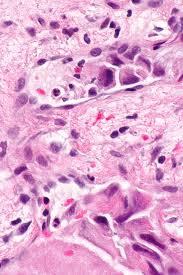
рак гортани

Международная классификация стадий рака гортани
Рак гортани занимает первое место в списке опухолей головы, шеи. Этот вид онкологии наиболее часто поражает мужчин от 40 до 75 лет. Симптоматика заболевания и особенности его лечения отличаются зависимо от его этапа, поэтому следует подробнее рассмотреть особенности стадирования, а также ознакомиться с методами профилактики и статистикой выживаемости.
Содержание:
- Международная классификация стадий рака гортани
- Какие симптомы рака гортани возникают на различных стадиях?
- Специфика диагностики и лечения рака гортани на разных стадиях
- Методы профилактики рака гортани
- Прогнозы при раке гортани
Международная классификация стадий рака гортани
Для выявления и последующего лечения рака за границей используется международная классификация МКБ-10, разработанная ВОЗ. Рак гортани в МКБ-10 обозначается С 32.0 - С 32.9. Помимо этого, применяется общепринятая система TNM, описывающая:
- клеточную природу, форму новообразования;
- место расположения опухоли;
- масштабы распространения.
В онкологии принято выделять следующие стадии:
- I – новообразование расположено в границах 1 анатомической области;
- II – новообразование полностью поразило один отдел гортани, но без метастазирования;
- IIIa – атипичные клетки прорастают в ткани по соседству, ограничивая естественную подвижность гортани;
- IIIb – то же, что и при IIIa, только в развитие опухоли могут вовлекаться регионарные лимфоузлы;
- IV стадия – начало процесса метастазирования и проникновения опухоли в отдаленные части тела.
Какие симптомы рака гортани возникают на различных стадиях?
Признаком предракового состояния или так называемой нулевой стадии является незначительное изъязвление слизистых оболочек, при этом явные симптомы могут отсутствовать.
- Рак гортани 1 стадии: ощущается дискомфорт в горле при глотании и разговоре (без ощутимых изменений голоса). Расположение опухоли возможно как на поверхности (в виде небольшой язвочки), так и в подслизистых слоях.
- Рак гортани 2 стадии: появляются стойкая осиплость голоса и заметное ухудшение речи. Естественная подвижность гортани сохраняется.
- Рак гортани 3 стадии: охваченный онкологическим процессом отдел гортани постепенно теряет свою подвижность. Появляются боль и сильный кашель, происходит потеря голоса (частично или в полной мере).
- Рак гортани 4 стадии: опухоль имеет достаточно обширные размеры. В шейных лимфоузлах прощупываются многочисленные метастазы, при этом процесс метастазирования охватывает и отдаленные органы. Характерны полная потеря голоса, непрекращающаяся боли при глотании и даже дыхании.
На скорость развития заболевания непосредственно влияет возраст пациента. У молодых людей наблюдается ускоренное течение рака гортани.
Помимо этого, на симптоматику непосредственно влияет изначальное месторасположение опухоли:
- На ложных голосовых связках: длительное время не проявляет каких-либо симптомов;
- На истинных голосовых связках: сразу же ведет к нарушению процессов воспроизведения звуков: грубеет тембр, появляется хрипотца. Без должного лечения голос понижается до шепота. Появляются одышка и боль при проглатывании еды и напитков;
- На надгортаннике или черпаловидных хрящах: наиболее ранний симптом - хрипота, переходящая в устойчивое ощущение боли и нарастающее чувство постороннего объекта, что вызывает дискомфорт. Через некоторое время могут появиться кровянистое отделяемое и устойчивые затруднения при приеме пищи. Ощущается гнилостный запах, происходит резкая потеря веса, нарастает слабость.
Специалисты рекомендуют незамедлительно обратиться к отоларингологу при проявлении одного или нескольких симптомов из этого перечня:
- потеря веса, не связанная с изменением р
ациона или занятиями спортом; - изменения в голосовом аппарате (осиплость, охриплость), а также длительный кашель;
- затруднения или болевые ощущения при дыхании или глотании;
- постоянная боль в горле либо боль, отдающая в ухо;
- на шее прощупывается новообразование (узелок).
Специфика диагностики и лечения рака гортани на разных стадиях
Гортань находится достаточно глубоко, поэтому диагностика и лечение имеют определенные трудности, сегодня решаемые применением специальных ЛОР-инструментов и современных технологий.
Процедуры, используемые при диагностике
Ключевыми диагностическими методиками, применяемыми для выявления рака гортани, являются следующие:
- Ларингоскопия и трахеоскопия
Аппаратное обследование проходит с помощью гибкой и тонкой трубки, оснащенной видеокамерой и осветителем.
- Биопсия (пункция)
Если в результате осмотра обнаруживается подозрительный очаг или новообразование, врач берет образец пораженной ткани для дальнейшего исследования. Биопсия - это единственная технология, помогающая определить присутствие раковых клеток и понять особенности их строения.
- Компьютерная томография (КТ)
Показана для определения точных размеров новообразования и его распространенности в лимфоузлы и окружающие ткани.
- Позитронно-эмиссионная томография, совмещенная с компьютерной (ПЭТ-КТ)
Наиболее современная технология, помогающая точно понять стадию рака, обнаружить наименьшие метастазы и при необходимости откорректировать курс лечения. В некоторых случаях ПЭТ-КТ назначают повторно для проверки процесса выздоровления спустя 9-12 недель после полного завершения предусмотренной программы.
Если опухоль гортани дала отдаленные метастазы, то для диагностирования дополнительно используются методы, наиболее соответствующие их местоположению.
Процедуры, используемые при лечении
Программу лечения составляет онколог-отоларинголог, учитывая тип и степень распространения опухоли. Немаловажными факторами считаются: возрастные особенности, текущее состояние здоровья пациента и наличие сопутствующих патологий.
- Хирургия
При раннем выявлении заболевания, наиболее результативным способом лечения признано оперативное удаление опухоли. Способы хирургического вмешательства разнятся и нередко зависят от возможностей выбранной клиники. Именно поэтому малоинвазивные операции высокого уровня сложности пациентам чаще всего доступно при лечении за рубежом. Виды операций при раке гортани: хордэктомия, гемиларингоэктомия, частичная и полная ларингоэктомия, тиреоидэктомия, а также удаление с помощью лазера. Если болезнь запущена, хирурги могут удалить пораженные голосовые связки и язык (частично или целиком).
- Радиотерапия (облучение)
Используется для дооперационного лечения. Она позволяет уничтожить опухоль посредством высокочастотных рентгеновских лучей, а также других типов излучения.
- Химиотерапия
Она используется в качестве самостоятельного лечения и рекомендуется к применению в послеоперационный период либо в сочетании с облучением.
- Комбинированное лечение
Наиболее часто используемая методика, предусматривающая прохождение лучевой терапии для уменьшения размеров опухоли с последующим ее удалением хирургическим путем и закреплением результата с помощью химиотерапии.
Методы профилактики рака гортани
Для профилактики перерождения здоровых клеток в злокачественные необходимо:
- Отказаться от курения, употребления спиртного;
- При обнаружении характерных симптомов своевременно обращаться за помощью к специалисту, не допуская осложнений;
- Регулярно проходить профилактический осмотр;
- Если работа связана с вредным производством, неукоснительно соблюдать все меры предосторожностей;
- Уделять внимание гигиене полости рта;
- Избегать контакта с токсичными веществами, отличающимися повышенной канцерогенностью;
- Откорректировать рацион, исключив нехватку витаминов группы В и А.
Прогнозы при раке гортани
Выявление заболевания на ранних стадиях значительно повышает шансы на полное излечение и отсутствие рецидивирования в будущем. Для оценки результативности терапии врач составляет 5-летний прогноз выживаемости, при котором учитываются начальная стадия рака гортани и индивидуальный отклик организма на терапию:
- При 0 стадии вероятность полного выздоровления составляет около 100%;
- При 1 стадии - 80-85%;
- При 2 - 70-75%;
- При 3 - 50%;
- При 4 - 20-25%.
На заключительном этапе болезни успех лечения зависит от пациента - требуется радикальное удаление пораженных органов (гортани и голосовых связок) - ларингоэктомия. К сожалению, после данной операции он становится немым, однако таким образом остается шанс на выздоровление.
При лечении в Израиле больные могут рассчитывать на максимально положительные прогнозы при таком раке, а также на полное восстановление естественных функций организма. Израильские специалисты достигают высочайших результатов в борьбе с различными видами рака и его последствиями. Пациенты имеют возможность пройти курс реабилитации с обучением речевым навыкам. Если после удаления масштабной опухоли человек не может дышать самостоятельно, то выполняется трахеостомия, возвращающая дыхательную функцию с помощью особой трубки.

WhatsApp Сообщение




